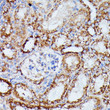
Immunohistochemistry analysis of IDH3A in paraffin-embedded mouse kidney using IDH3A Rabbit polyclonal antibody (STJ116856) at dilution of 1:100 (40x lens). Perform microwave antigen retrieval with 10 mM PBS buffer pH 7. 2 before commencing with immunohistochemistry staining protocol.

Anti-IDH3A antibody (28-366) (STJ116856)
SPECIFICATIONS
ClonalityPolyclonal
HostRabbit
ConjugationUnconjugated
IsotypeIgG
General Information
| Short Description | Rabbit polyclonal IDH3A (28-366) antibody for use in WB, IHC-P, IF, ICC and ELISA in human, mouse and rat samples. Datasheet included with dilution recommendations, and related reagents. |
| Applications | WB/IHC-P/IF/ICC/ELISA |
| Host | Rabbit |
| Reactivity | Human/Mouse/Rat |
| Note | STRICTLY FOR FURTHER SCIENTIFIC RESEARCH USE ONLY (RUO). MUST NOT TO BE USED IN DIAGNOSTIC OR THERAPEUTIC APPLICATIONS. |
Product Properties
| Clonality | Polyclonal |
| Isotype | IgG |
| Conjugation | Unconjugated |
| Concentration | Lot specific |
| Purification | Affinity purification |
| Dilution Range | WB:1:500-1:2000IHC-P:1:50-1:200IF/ICC:1:50-1:200ELISA:Recommended starting concentration is 1 Mu g/mL. Please optimize the concentration based on your specific assay requirements. |
| Formulation | PBS with 0.01% Thimerosal, 50% Glycerol, pH 7.3. |
| Storage Instruction | Store at-20°C for up to 1 year from the date of receipt, and avoid repeat freeze-thaw cycles. |
Target Information
| Gene Symbol | IDH3A |
| Gene ID | 3419 |
| Uniprot ID | IDH3A_HUMAN |
| Immunogen Region | 28-366 |
| Immunogen Sequence | TGGVQTVTLIPGDGIGPEIS AAVMKIFDAAKAPIQWEERN VTAIQGPGGKWMIPSEAKES MDKNKMGLKGPLKTPIAAGH PSMNLLLRKTFDLYANVRPC VSIEGYKTPYTDVNIVTIRE NTEGEYSGIEHVIVDGVVQS IKLITEGASKRIAEFAFEYA RNNHRSNVTAVHKANIMRMS DGLFLQKCREVAESCKDIKF NEMYLDTVCLNMVQDPSQFD VLVMPNLYGDILSDLCAGL |
| Specificity | Recombinant fusion protein containing a sequence corresponding to amino acids 28-366 of human IDH3A (NP_005521.1). |
Additional Info
| Function | Catalytic subunit of the enzyme which catalyzes the decarboxylation of isocitrate (ICT) into alpha-ketoglutarate. The heterodimer composed of the alpha (IDH3A) and beta (IDH3B) subunits and the heterodimer composed of the alpha (IDH3A) and gamma (IDH3G) subunits, have considerable basal activity but the full activity of the heterotetramer (containing two subunits of IDH3A, one of IDH3B and one of IDH3G) requires the assembly and cooperative function of both heterodimers. |
| Protein Name | Isocitrate Dehydrogenase Nad Subunit Alpha - MitochondrialIsocitric Dehydrogenase Subunit AlphaNad(+-Specific Icdh Subunit Alpha |
| Database Links | Reactome: R-HSA-71403Reactome: R-HSA-9837999 |
| Cellular Localisation | Mitochondrion |
| Alternative Antibody Names | Anti-Isocitrate Dehydrogenase Nad Subunit Alpha - Mitochondrial antibodyAnti-Isocitric Dehydrogenase Subunit Alpha antibodyAnti-Nad(+-Specific Icdh Subunit Alpha antibodyAnti-IDH3A antibody |
Information sourced from Uniprot.org